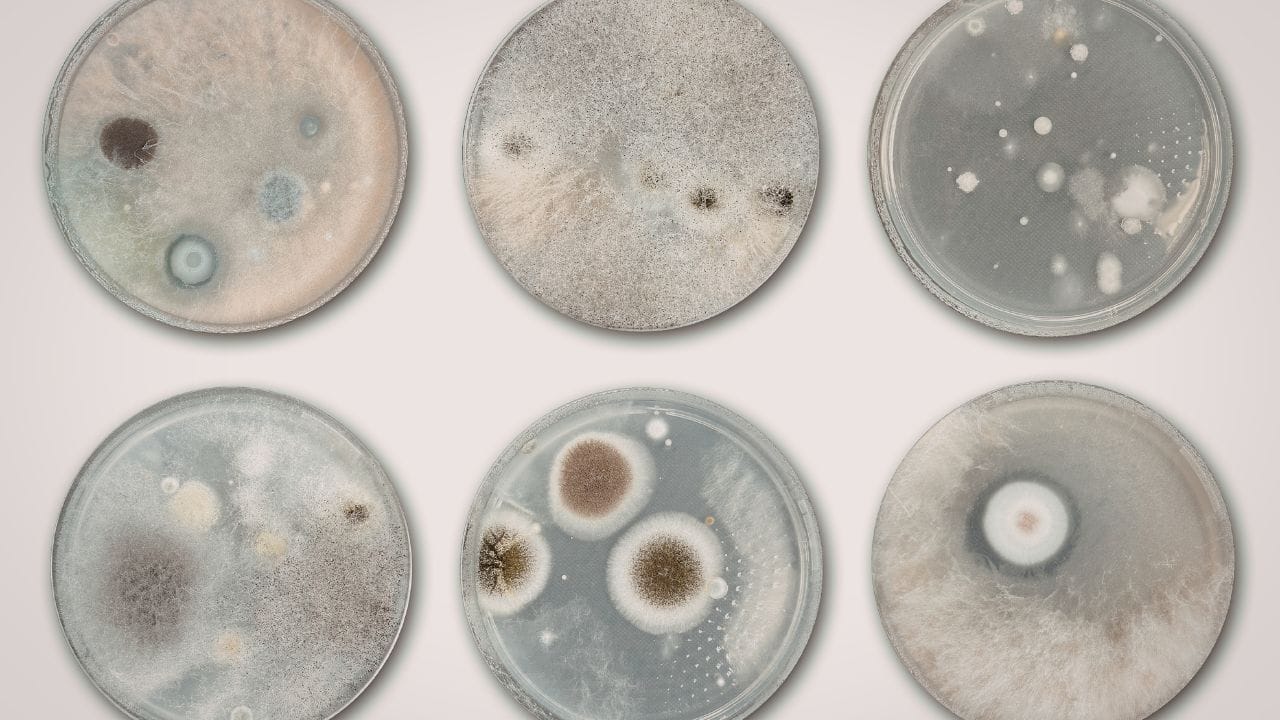

Join 100+ customers, farmers & partners growing with Fruvini
India’s Integrated Mushroom Agri-Wellness Ecosystem
From sustainable farming to functional foods, training, and smart agriculture — Fruvini connects nature, science, and wellness.

What is Fruvini?
Fruvini is a next-generation agri-wellness venture focused on premium mushroom cultivation, value-added food products, farmer training, and smart farming solutions.
We combine scientific methods, sustainable practices, and Ayurveda-inspired wellness to create high-quality products and meaningful rural experiences.
Our Integrated Solutions
From cultivation to consumption, training to technology — Fruvini delivers a complete ecosystem built around sustainable mushrooms, wellness, and smart agriculture.

🍄 Fresh & Gourmet Mushrooms
Carefully cultivated, high-quality mushrooms grown in controlled environments to ensure purity, consistency, and superior nutrition.

🥣 Functional Foods & Value-Added Products
Nutrient-rich mushroom powders, dried varieties, ready-to-cook mixes, and wellness-focused food innovations for modern lifestyles.
🧪 Fruvini BioLabs
In-house spawn production and research-driven cultivation practices to maintain quality, improve strains, and ensure reliable yields.

🎓 Fruvini Academy
Practical training programs and expert guidance to help farmers and entrepreneurs succeed in mushroom cultivation.

🤖 SmartFarm Technology
Advanced monitoring and automation systems designed to optimize farm conditions, increase productivity, and reduce risk.

Visit the Fruvini Experience Hub
Explore our farm, taste fresh mushroom-based foods, attend workshops, and connect with nature through our agrotourism experiences.
Why Fruvini?
- Scientifically grown, contamination-free mushrooms
- Sustainable and eco-friendly farming
- Ayurveda-inspired wellness approach
- Integrated ecosystem: Farm + Food + Training + Technology

Got Questions? We’ve Got Answers
What makes Fruvini mushrooms different?
Our mushrooms are grown in controlled environments using scientific methods, ensuring consistent quality, hygiene, and high nutritional value — free from harmful chemicals.
Do you offer training for beginners?
Yes. Fruvini Academy provides hands-on training and guidance for beginners, farmers, and entrepreneurs who want to start or scale mushroom cultivation.
What types of mushroom products do you offer?
We offer fresh mushrooms, dried varieties, mushroom powders, ready-to-cook mixes, and other value-added wellness products.
Can I visit your farm or attend workshops?
Absolutely. Through our Fruvini Experience Hub, you can join farm visits, workshops, and learning sessions designed for individuals, families, and organizations.
Do you supply to restaurants or bulk buyers?
Yes, we provide bulk supply of fresh and processed mushroom products to restaurants, retailers, and distributors.
What is SmartFarm and how does it help farmers?
SmartFarm is our upcoming IoT and AI-based platform that helps farmers monitor farm conditions, improve yield, and reduce risks through data-driven insights.
Start Your Journey with Fruvini
Whether you’re a customer, farmer, or partner — join us in building a healthier and more sustainable future.
